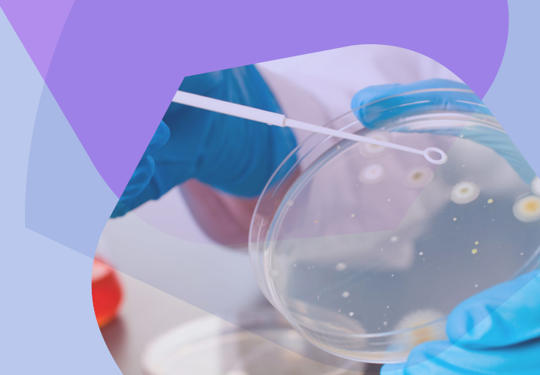
Infection Management

World Antibiotic Awareness week Nov 18 – 25 is a call to arms to mitigate the growth of antimicrobial resistance- which has risen by 9.3% in the last few years.
Infections cause around 90,000 deaths nationally a year – similar to ischaemic heart disease – with just under 10% attributable to antimicrobial resistance. Tackling this complex challenge will require a broad approach centred around optimal infections management.
Why a focus on infections is mission critical
Infections are the most common reason for emergency hospital admission
In England, infections cause nearly 2 million admissions per year (out of a total of 6 million), are the admission reason for half of NHS bed days and 2/3rd of hospital deaths. They have also grown by 50% over the last 5 years. The pandemic taught us many things, but hidden within was the fact that the majority of infection admissions – even during this period – were caused by common bacteria, and that greater focus on infections is required across all systems across all seasons but particularly winter.
Infections are treated by physicians of all specialties with 1/3rd of inpatients being treated with antibiotics at any point of time and 80% having had a course of antibiotics during their hospital stay. They are directly linked to nearly all specialties – as either a cause of deterioration or complication of treatment. As a result, it is vital that we all work to identify, prevent, mitigate and treat infections in our patient groups with the lens of providing optimal infection management.
Optimal Infections Management
Infection management consists of infection prevention, assessment, diagnostics and treatment. These elements are interlinked and colleagues working in these areas should be brought together at national, regional and local levels.
The traditional silo working must be challenged in order to improve collaboration and find solutions to common problems; and pivotal to this is the engagement of prescribing clinicians who have direct ongoing responsibility for patient care.
Antimicrobial Resistance
AMR is no longer just a problem for tomorrow, with rates having risen by 10% in recent times, and though directly related deaths are currently rare (less than 10%), AMR deaths are projected to match those due to Cancer by 2050. Whilst new treatments and cures for cancer continue at rapid pace, there have not been similar strides to develop new antibiotics. As a result, it is crucial we focus on infection management strategies (prevention, clinical guidance, diagnostic tests and antimicrobial stewardship) to treat appropriately, with narrow spectrum antibiotic choices and for the correct duration.
Sepsis
There are plans afoot to develop a national modern framework for sepsis, and though this is welcome news – we must be careful to balance this against AMR. Incentivising sepsis care can have the side effect of both artificial increases in diagnosis and increasing broad spectrum antibiotic usage in patients without even an infection.
AMR and Sepsis – Two sides of the same coin
Clinicians and patients do not view them as isolated, and they should not be led separately, and by creating policy around optimal infections care, both can be addressed within a more unified, balanced and pragmatic approach. Indeed, the patients that develop AMR are also more likely to develop sepsis.
Clinical realities
Clinical medicine is rife with uncertainty, not least in the acute or emergency arena, where there is potential harm from not administering antibiotics and it is commonplace to prescribe antibiotics ‘just in case’.
‘No one ever went to coroners court for giving a patient an antibiotic'
It is vital that we support the use of clinical judgement of infection and starting them where appropriate, stopping them early once infection has been ruled out. It is also crucial that those setting guidelines realise that it is often extremely challenging to review patients on a busy acute take, and that decisions over treatment are often made on the basis of a single assessment. Perhaps, the better opportunity is on the post take consultant review when more results are back, more monitoring has been undertaken and there has been a response to treatment.
We are far away from a sepsis test and clinical guidance should be based on perceived risk of patient, clinical conviction of infection, illness severity and supporting diagnostics (including host-response biomarkers that can assist decision making e.g. CRP, WBC, procalcitonin).
We should consider sepsis when patients deteriorate, but must be aware that not all deteriorations are due to sepsis – and of the potential harms that can occur if we do not consider a more balanced approach.
As we celebrate World Antibiotic Awareness week, we should pause and reflect on the incredible strides we have made due to having effective antibiotics and the potential harms of losing this vital treatment. Returning to a pre penicillin age where patients died from treatable bacterial infections would be quite simply disastrous for humanity.
Work must be put in to develop rapid point of care diagnostic tests and physiological scores in all settings to support but not replace clinical judgement with large scale research undertaken to ascertain who is at risk, what can be prevented, mitigated and how this can be done.
Critical to these efforts is listening to and collaborating with prescribing physicians with direct patient responsibility, who shoulder the risks of missing severe infections, and provide the holistic infections clinical care that is so pivotal to achieving optimal outcomes.